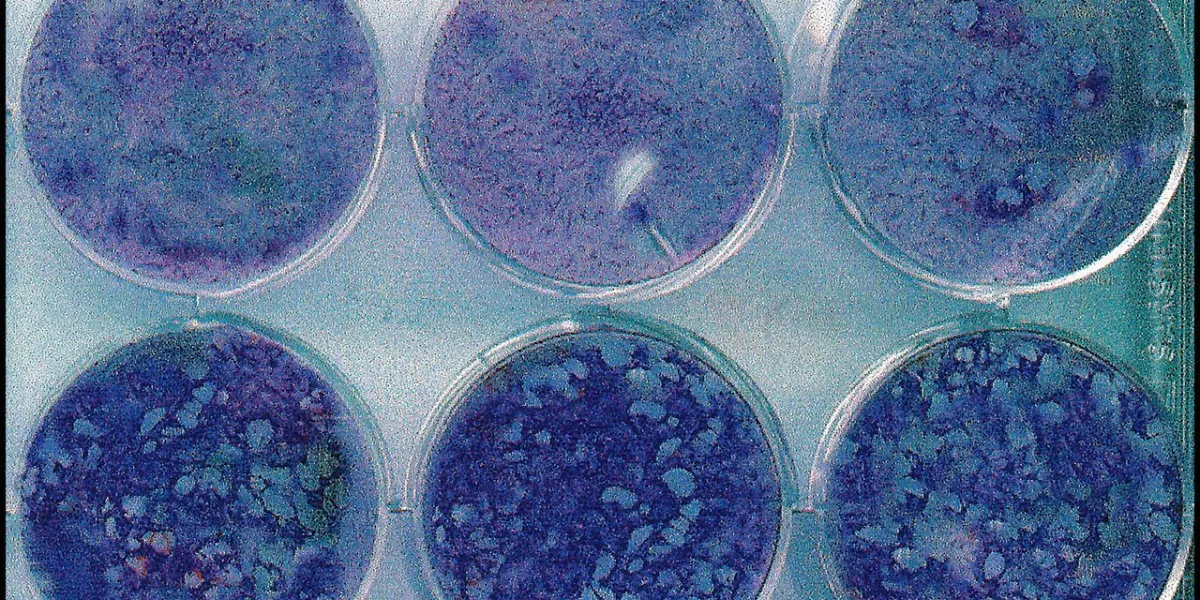

Maladies
Cancer
Image

Troubles de la circulation sanguine
Digestion et Transit Intestinal
Ostéoporose
Rhumatismes et Articulations
Image

Image

Image

Addictions
Allergies
Maladies cardiovasculaires
Image

Maladies de peau
Image

Image

Maladies des yeux
Maladies neurologiques
Image

Maladies ORL et respiratoires
Maladies du sang
Maladies du dos
Maladies des reins et de l'appareil urinaire
Image